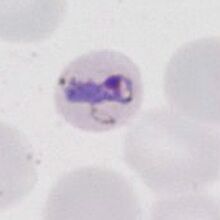

Ring forms
From haematologyetc.co.uk
What is a ring form?
The earliest stage following red cell invasion has a typical ting form:
- a = chromatin dot
- b = digestive vacuole
- c = parasite cytoplasm
Description
At the earliest stage of red cell infection parasites of all species have the form of a "ring". Distinction between species at this stage may not be easy (or even possible). However as the parasite mature and develop differences between species become more apparent. In some species the ring appearance is maintained until late stages of maturation, in others there is loss of a typical ring appearance
- P.falciparum: Typically the rings small and delicate, rings tend to persist from early trophozoite until late stages although they may thicken
- P.ovale: Typical rings are large and robust and this shape may persist until late stages of development (contrast with P.vivax)
- P.malariae: Rings are small but more substantial that P.falciparum becomeing solid or bad and losing the ring appearance as they develop
- P.knowlesi: Early forms resemble P.falciparum; as they mature they often extend and become solid or band-like resembling P.malariae
- P.vivax: Early stages appear as rings becoming irregular then eventually taking on a more typical amoeboid appearance at later stages
These changes can be very useful in identifying the different malaria species; these are illustrated for maturing trophozoites below:
P.falciparum
Small and often delicate rings that thicken at later developmental stages although they remain relatively small with a "ring appearance". Note that the red cell size is unchaged and not distorted, also the appearance of characteristic Maurer's dots and clefts within the red cell cytoplasm as the parasites develop. Most frequently only the early developmental stage will be detected in blood
P.vivax
The trophozoites are usually present at all developmental stages, during parasite development they become solid and irregular developing an increasingly amoeboid appearance. During this development the red cells become markedly enlarged and distorted, with characteristic Schüffner's dots.
P.ovale
The rings are larger and more robust than in P.falciparun, and they enlarge further during parasite development although in this species the characteristic ring appearance can often still be distinguished even late in development. Note that red cells become enlarged and distorted (typically elongation and fimbriation) with characteristic James' dots.
P.malariae
The rings are small but generally appear more robust than P.falciparum, the parasites become more solid often losing the central digestive vacuole and may become angular or extend as a band across the cells. Red cells are not enlarged or distorted and may be reduced in size in this species
P.knowlesi

small or normal P.malariae (round)